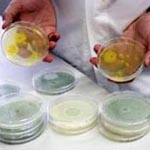
Новый вид заменителя сахара может помочь в борьбе с ожирением

Проблема ожирения в современном мире особенно актуальна. Вопреки факту, что человек стал потреблять гораздо больше пищи, чем несколько десятилетий назад, все же это не является единственной причиной развития ожирения. Главной же причиной ученые называют огромное количество углеводов в еде, которые усваиваются организмом весьма быстро, а также недостаточно активный образ жизни большинства людей. Специалисты из Вены заявляют, что выход из данной ситуации, похоже, найден.
Проблема ожирения в современном мире особенно актуальна. Вопреки факту, что человек стал потреблять гораздо больше пищи, чем несколько десятилетий назад, все же это не является единственной причиной развития ожирения. Главной же причиной ученые называют огромное количество углеводов в еде, которые усваиваются организмом весьма быстро, а также недостаточно активный образ жизни большинства людей. Специалисты из Вены заявляют, что выход из данной ситуации, похоже, найден.
Учеными из австрийского технологического университета была выявлена формула нового заменителя сахара. Он был получен путем изменения структуры эритрита, а изготовлен подсластитель на основе обычных дрожжей, потому его смело можно называть натуральным. Вещество состоит из патоки, которая взаимодействует с безвредной плесенью Trichoderma reesei.
Готовый продукт практически схож по вкусу с обыкновенным сахаром, но польза его огромна. Ученые надеются, что новый вид подсластителя сыграет большую роль в борьбе с избыточным весом.